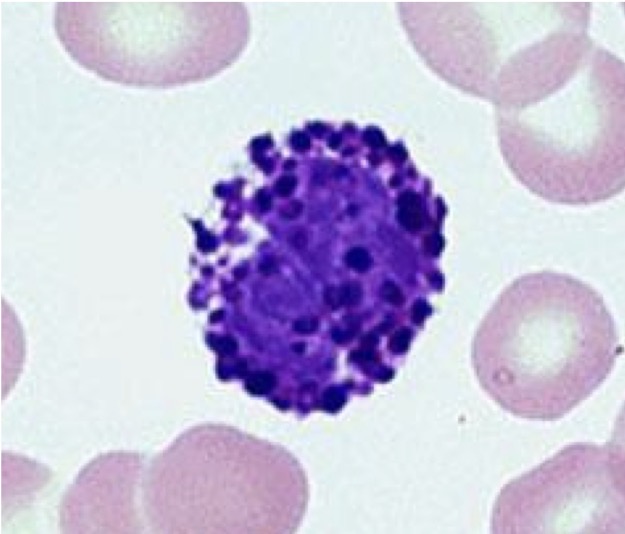
term image
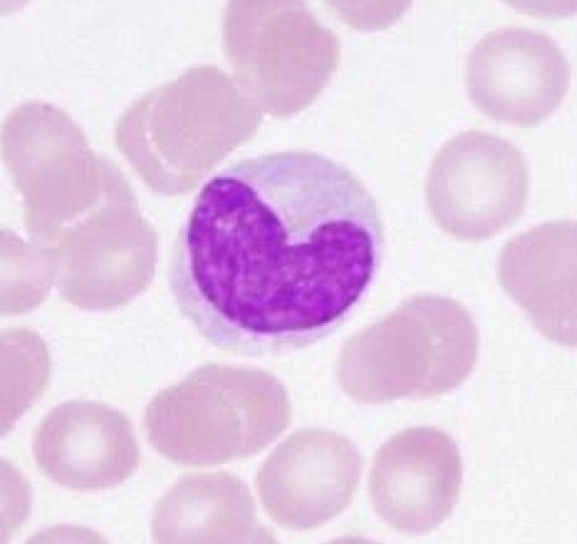
term image
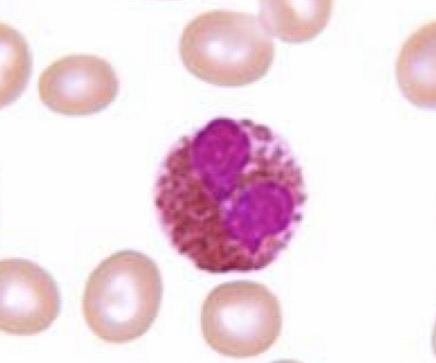
term image
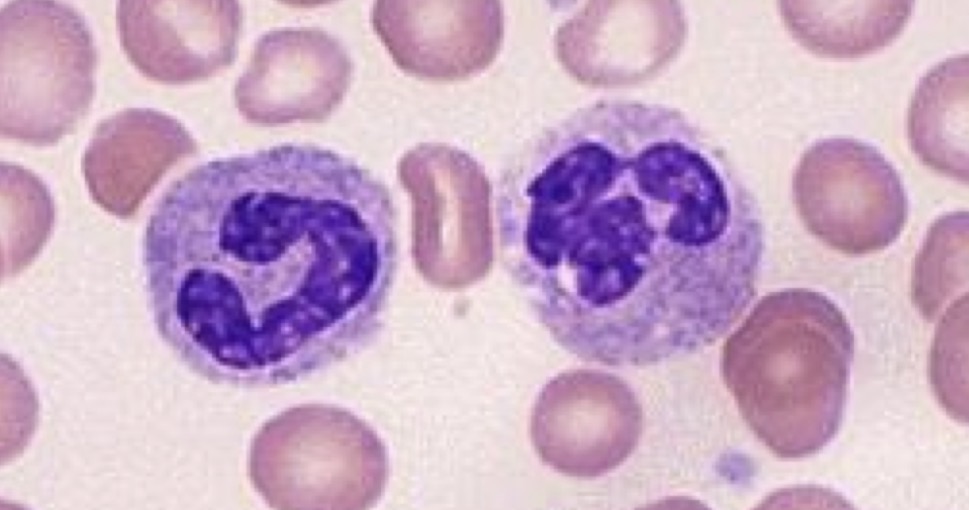
term image
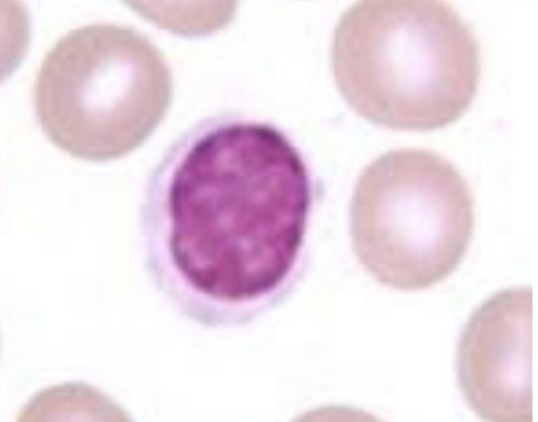
term image
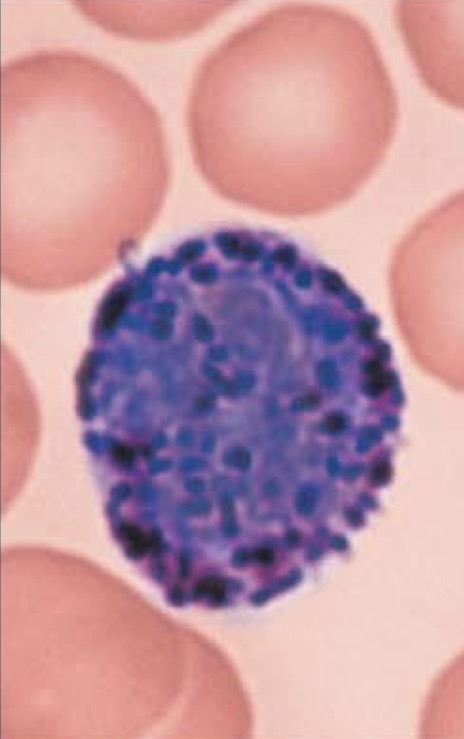
term image

A&P II Lab Practical 1 & 2
1/68
There's no tags or description
Looks like no tags are added yet.
Name | Mastery | Learn | Test | Matching | Spaced | Call with Kai |
|---|
No analytics yet
Send a link to your students to track their progress
69 Terms
Basophil
Monocyte
Eosinophil
Neutrophil
Lymphocyte

Neutrophil

Eosinophil
Basophil

Monocyte

Lymphocyte

right coronary a.

Left coronary a.

Anterior interventricular branch of left coronary a.

Circumflex branch of left coronary a.

Great cardiac v.

Coronary sinus

Anterior interventricular sulcus

Chordae tendinae

Papillary muscle

Trabeculae carnae

Anterior cerebral a. and branches

Posterior cerebral a. and branches

Basilar a.

Vertebral a.

Left common carotid a.

Left external carotid a.

Left internal carotid a.

Left external jugular v.

Left internal jugular v.

Brachiocephalic trunk

Left subclavian a.

Right subclavian a.

(Left) axillary a.

(Left) brachial a.

(Left) radial a.

(Left) ulnar a.

Left brachiocephalic v.

Right brachiocephalic v.

Left subclavian v.

Right subclavian v.

(Left) axillary v.

(Left) brachial v.

(Left) radial v.

(Left) ulnar v.

Abdominal aorta

Inferior vena cava

Left renal a.

Left renal v.

(Left) common iliac a.

(Left) external iliac a.

(Left) femoral a.

(Left) common iliac v.

(Left) external iliac v.

(Left) femoral v.

(Left) Great saphenous v.

Hypothalamus

Pituitary gland

Thyroid gland

Suprarenal gland (adrenal gland)

Pancreas

Testis

Ovaries

Pharyngeal tonsil

Lingual tonsil

Palatine tonsil

Spleen

Axillary lymph nodes

Mediastinal lymph nodes

Peyer’s patch (lymph nodes) of ileum